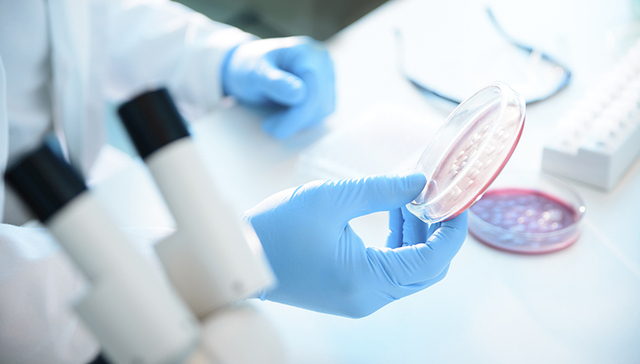
世卫组织：国际专家组所有成员预计本周末抵华协助抗击新冠肺炎

文 |
世界卫生组织总干事谭德塞14日宣布,协助中国抗击新冠肺炎的国际专家组所有成员预计本周末抵达中国。
正在刚果(金)访问的谭德塞当天在线出席在日内瓦举行的世卫组织例行记者会。谭德塞说,世卫组织牵头的国际专家组与中方专家的合作进展顺利,国际专家组所有成员预计本周末抵达中国。
由加拿大流行病学家和应急专家布鲁斯·艾尔沃德率领的国际专家组首批成员已于10日抵达中国。
谭德塞介绍说,届时12名来自世卫组织和全球各地的专家将与规模相当的中国专家共同组成一支联合专家组。联合专家组将着重了解病毒的传播特性、疾病的严重程度以及目前采取的应对措施所发挥的作用,其主要目标是对中国以及全球在抗击新冠肺炎疫情中的下一步应急和准备工作给出建议,让全球其他地区利用这一“机会窗口”,为卫生系统和医护人员应对未来可能蔓延的疫情做好准备。
谭德塞还透露,联合专家组将访问3个省份,实地了解地方政府应对举措的实施情况和作用等。

谭德塞表示,很高兴看到与一周前相比,世界各国应对新冠肺炎的准备更加充分。世卫组织将继续努力,帮助各国提高实验室检测能力。